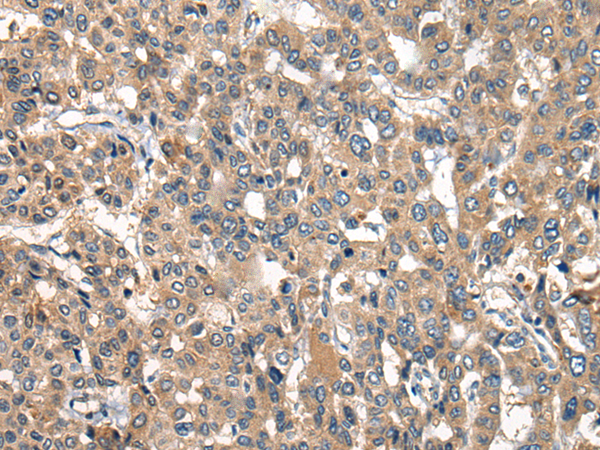
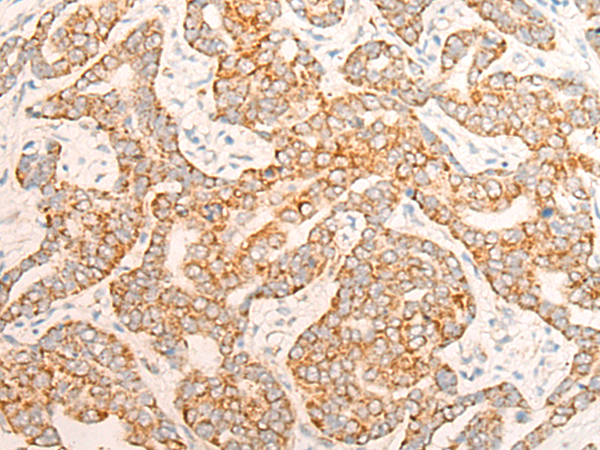

-
分类: 科研抗体货号: P13084别名: HCC1; THO1; CIP29; HSPC316应用: WB,IHC反应种属: Human, Mouse, Rat
-
分类: 科研抗体货号: P13112别名: CORONIN-2应用: IHC反应种属: Human, Mouse, Rat
-
分类: 科研抗体货号: P13100别名: CNG3; ACHM2; CCNC1; CCNCa; CNCG3; CCNCalpha应用: WB,IHC反应种属: Human
-
分类: 科研抗体货号: P13111别名:应用: IHC反应种属: Human, Mouse, Rat
-
分类: 科研抗体货号: P13116别名: p100; p100OAS应用: IHC反应种属: Human
-
分类: 科研抗体货号: P13099别名: PCMT; PPMT; PCCMT; HSTE14; MST098; MSTP098应用: IHC反应种属: Human, Mouse, Rat
-
分类: 科研抗体货号: P13110别名: RCOR; COREST应用: WB,IHC反应种属: Human, Mouse
-
分类: 科研抗体货号: P13115别名: WT6; XBR; NRSF应用: WB反应种属: Human
-
分类: 科研抗体货号: P13127别名: EPD; PDE; ATQ1应用: WB,IHC反应种属: Human, Mouse, Rat
-
分类: 科研抗体货号: P13109别名: RFWD2; RNF200应用: IHC反应种属: Human, Mouse

鄂公网安备42018502007531号
鄂公网安备42018502007531号

